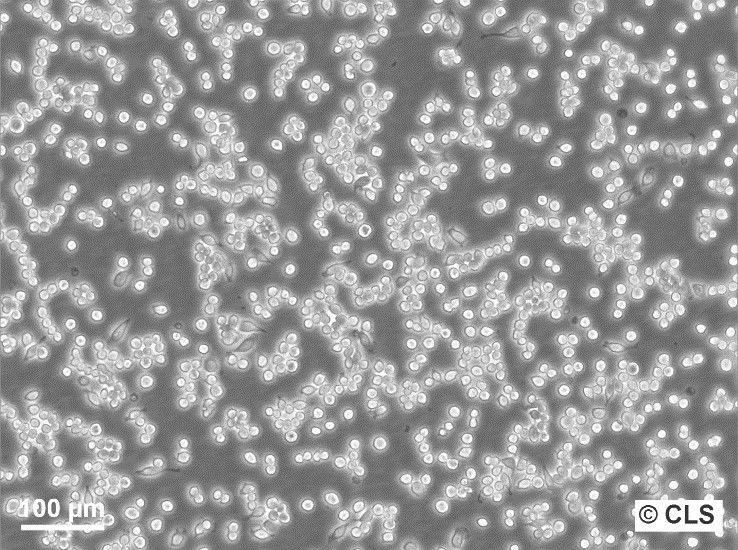
raw-264-7-(6)_1920x1920
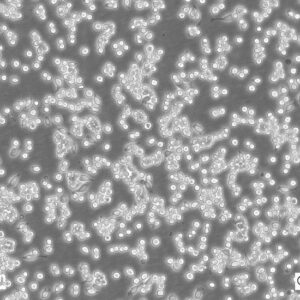

Supplier: CLS cell lines service, Germany
Cat no.: 400319
Amount: 1 cryovial
Organism: Mouse
Tissue: Ascites
Disease: Leukemia
Age: Adult
Gender: Male
Celltype: Macrophage
Growth Properties: Adherent
Discription: The RAW264.7 cell line was established from a preparation of macrophages of a BAB/14 mouse. Due to an infection with the Abelson-Mouse-Leukemia Virus (Ab-MLV) and an ecotropic MLV, the BAB/14 mouse had developed tumors. The macrophage-like cells will pinocytose neutral red and will phagocytose latex beads and zymosan. They are capable of antibody dependent lysis of sheep erythrocytes and tumor cell targets. LPS or PPD treatment for 2 days stimulates lysis of erythrocytes but not tumor cell targets.
History and Usage in Immunology
The RAW 264.7 cell line is an immortalized murine macrophage cell line, which was established from a tumor induced by the Abelson murine leukemia virus in an adult male mouse. Since its establishment, the cell line has been widely used in immunological and biological research due to its ability to differentiate and function similarly to primary macrophages.
In immunology experiments, RAW 264.7 cells have been employed for a variety of purposes:
- Response to Pathogens: These cells are often used to study macrophage responses to various bacterial, viral, and parasitic challenges. This includes phagocytic activity, production of reactive oxygen species, and secretion of cytokines and chemokines.
- Signal Transduction Studies: The cell line serves as a model to study signaling pathways activated or repressed during macrophage activation, such as the NF-kB pathway or MAP kinase pathways.
- Inflammation and Immune Modulation: Researchers use RAW 264.7 cells to evaluate the anti-inflammatory or pro-inflammatory effects of drugs, natural products, and other compounds. The production of nitric oxide (NO) and various cytokines in these cells can be measured as indicators of inflammatory response.
- Bone Resorption: Given their macrophage lineage, RAW 264.7 cells can differentiate into osteoclast-like cells, allowing researchers to study bone resorption mechanisms and potential therapeutic interventions for diseases like osteoporosis.
- Phagocytosis: As macrophages are professional phagocytes, RAW 264.7 cells are used to study mechanisms of phagocytosis and effects of different agents on this process.
- Drug and Toxicology Studies: Their wide use includes assessing the cytotoxicity of compounds or understanding drug mechanisms, especially those related to immune modulation.
In summary, the RAW 264.7 cell line holds a significant place in immunological research. Its versatility and robustness allow for diverse experimental applications, making it a fundamental tool in understanding macrophage biology and immune responses.
Product information: Buy RAW 264.7 | Cell Lines | CLS.shop
| Vendor | CLS – Cell Lines Service, Germany |
|---|
Related products
Tissue Culture
Tissue Culture
Tissue Culture
Tissue Culture
Tissue Culture
Tissue Culture
Tissue Culture